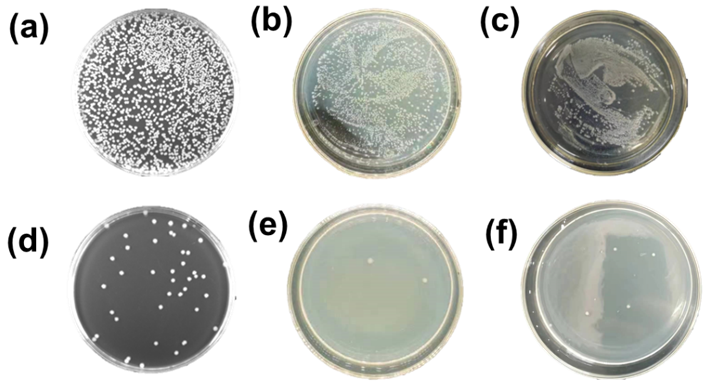

近年来,能源市场发生了巨大的变化,化石燃料正在被更清洁的能源所取代。核能具有技术成熟、成本低、可持续性等一系列的优点,与水电、光伏和风力发电相比,核能不存在供应间歇性,受自然条件限制较小。所以,它被认为是一种可以在很大程度上取代化石能源的清洁能源。然而,已探明的陆地铀矿只够现有的核电站运行80-120年,所以未来陆地铀燃料的匮乏无法避免。据统计,海水中含有铀约45亿吨,是陆地铀矿的几百倍。因此,从海水中提取铀是未来核能发展的重要一步。现在发展的从海水中提取铀的方法主要有吸附法、膜分离法、电化学萃取法,其中吸附法具有操作性好、应用范围广、经济效益高等多重优点。但是由于海水中铀浓度极低,且存在多种干扰金属离子和微生物种类,所以有必要开发一种新型高效吸附剂。

近日,郑州大学申长雨院士、刘春太教授团队的杨佩佩博士和李松伟博士课题组将采用氧化石墨烯(GO)和聚丙烯酰胺/聚丙烯酸(PAM/PAA)制备具有光热转化特性的水凝胶,用于从海水中高效提取铀。在PAM/PAA/GO水凝胶中引入两性离子2-甲基丙烯酰氧基乙基磷酸胆碱(MPC)得到PAM/PAA/GO/MPC(PAGM),具有良好的抗菌性能。PAGM展示了铀(VI)(U(VI))的有效和特异性吸附。光照条件下,PAGM的吸附容量达到196.12 mg g-1(pH = 8,t = 600 min, C0= 99.8 mg L-1, m/v = 0.5 g L-1)。吸附能力仅为160.29 mg g?1在黑暗条件下(pH = 8,t = 600 min,C0= 99.8 mg L-1, m/v = 0.5 g L-1)。光的吸附容量比暗光高22.5%。此外,PAGM在五次吸附-解吸循环后表现出良好的重复性和稳定性。在天然海水中储存一个月后PAGM的U(VI)吸附容量为6.1 mg g-1。X射线光电子能谱(XPS)结果表明, 氨基、羧基和羟基与U(VI)的配位是U(VI)吸附的主要机制,并通过详细的密度泛函理论计算证实了其机制。PAGM具有耐久性、高效率、光热转换性能和抗菌性能。
该工作以“Zwitterion functionalized graphene oxide/polyacrylamide/polyacrylic acid hydrogels with photothermal conversionand antibacterial properties for highly efficient uranium extraction from seawater” 为题发表在《Advanced Functional Materials》。文章第一作者是郑州大学硕士研究生李辉,该研究得到了国家自然科学基金项目和国家重点研发计划项目等项目的支持。
水凝胶的合成

图1. PAGM水凝胶合成工艺示意图
水凝胶的表征

图2. 气凝胶的表征
吸附性能

图 3. pH值、GO浓度、模拟阳光对于吸附的影响
理论密度泛函理论(DFT)计算

图4. 理论密度泛函理论(DFT)计算
抗菌性能测试
图5. 抗菌性能测试
全文链接:https://doi.org/10.1002/adfm.202301773
- 安徽理工大学/都柏林大学王文新教授团队 AFM 封面:刚柔协同网络如何兼顾水凝胶的可注射性与高韧性 2026-06-26
- 给水凝胶做“瑜伽”拉伸5次,透明又抗压,成果登上 Science Advances 2026-06-16
- 厦门大学林友辉/南洋理工大学吴荣辉团队 Nat. Commun.:逐层剪切致密化实现块体水凝胶多尺度层级排列 2026-06-17
- 天津大学杨建海/刘文广教授团队《Adv. Mater.》综述:两性离子聚合物 - 合成、结构、性能和生物医学应用 2026-06-10
- 浙江大学凌君教授课题组 Macromolecules:通过两性离子开环聚合制备可海水降解的环状聚半缩醛酯 2026-05-28
- 湖南工大陈一教授课题组 Nat. Commun.:拓扑缠结两性离子单网络水凝胶实现超弹性-超塑性的原位可逆转变 2026-05-25
- 湖北大学张玉红/陈朝霞、湖北工程学院刘勇Compos. Part B:具有光热转换、抗菌、耐久性超疏水海绵用于油水分离和原油回收 2025-09-30
